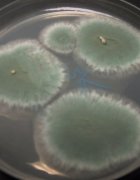

Rhapsody in Blue
Today, I’ll discuss an article, published early this month in Cell (october 8).


Today, I’ll discuss an article, published early this month in Cell (october 8).

Je ne résiste pas au plaisir de vous montrer une autre image de microscopie confocale…

Mignonne, allons voir si la rose Qui ce matin avait déclose Sa robe de pourpre au Soleil,

Je vais essayer de faire court…

Reprenons l’image de l’arbre précédemment invoquée pour représenter l’histoire de la vie. Appliquons-là aux cellules de notre organisme.

Des petites histoires particulières de l’évolution humaine, de son compagnonnage avec celle de nombreuses autres espèces
L’histoire de l’homme et de son alimentation offre de très beaux exemples d’évolution génétique, de sélection et d’adaptation.

Une fois n’est pas coutume, je vous propose une petite note un peu technique